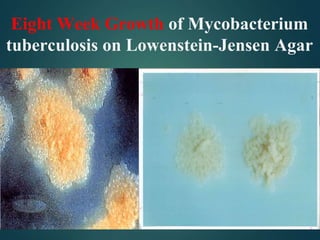
Eight Week Growth of Mycobacterium
tuberculosis on Lowenstein-Jensen Agar

The document provides an in-depth overview of tuberculosis (TB), focusing on its classification, pathogenesis, clinical manifestations, and laboratory diagnosis. It emphasizes the role of Mycobacterium tuberculosis, transmission methods, immune responses, and the differences between primary and secondary TB. Additionally, it discusses the epidemiology and drug resistance challenges in TB treatment, while outlining diagnostic methodologies such as microscopy and nucleic acid amplification tests.

![Methods for detection of IFN-y
Two new blood tests
1. T-SPOT.TB [Oxford Immunec] – directly count the no of
IFN-y secreting T cells.
2. QuantiFERON-TB Gold [Cellestis Limited] –
measures the concentration of IFNy secretion.
Both tests based on detection of IFN-y in blood have been found to be more accurate than
the tuberculin skin test in the diagnosis of latent TB infection. Future research should focus
on the potential efficacy of quantification of specifically activated lymphocytes in body
fluid and blood using IFN-Y release assay in the diagnosis of TB.](https://image.slidesharecdn.com/drbhavikatb-240614070016-281bda56/85/tb-pathogenesis-and-laboratory-diagnosis-pptx-65-320.jpg)












